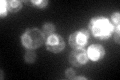
YMR123W
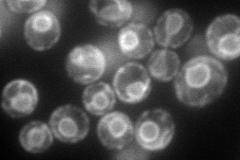
YMR123W
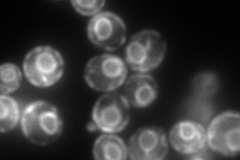
YMR123W
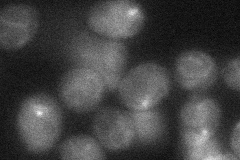
YMR123W
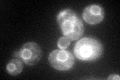
YMR123W
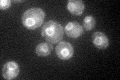
YMR123W

View description
V-ATPase assembly factor, functions with other V-ATPase assembly factors in the ER to efficiently assemble the V-ATPase membrane sector (V0)
Localization:
Intensity:
Fold change:
Significance:
-
C’ GFP library in SD
ER81.26 -
N' NOP1pr-GFP in SD
ER139.233 -
N' TEF2pr-mCherry in SD
ER352.634 -
N' NATIVEpr-GFP in SD

ER69.9425 -
N' TEF2pr-VC and Cyto-VN in SD
ER35.7896 -
C’ GFP library in SD+DTT

ER73.520.9No -
C’ GFP library in SD+H2O2
ER108.51.33No -
C’ GFP library in Starvation Media
ER74.690.91No -
C’ GFP library on the background of Pup2-DaMP

N/A -
C’ GFP library on the background of CCT mutant

N/A0N/AYes
